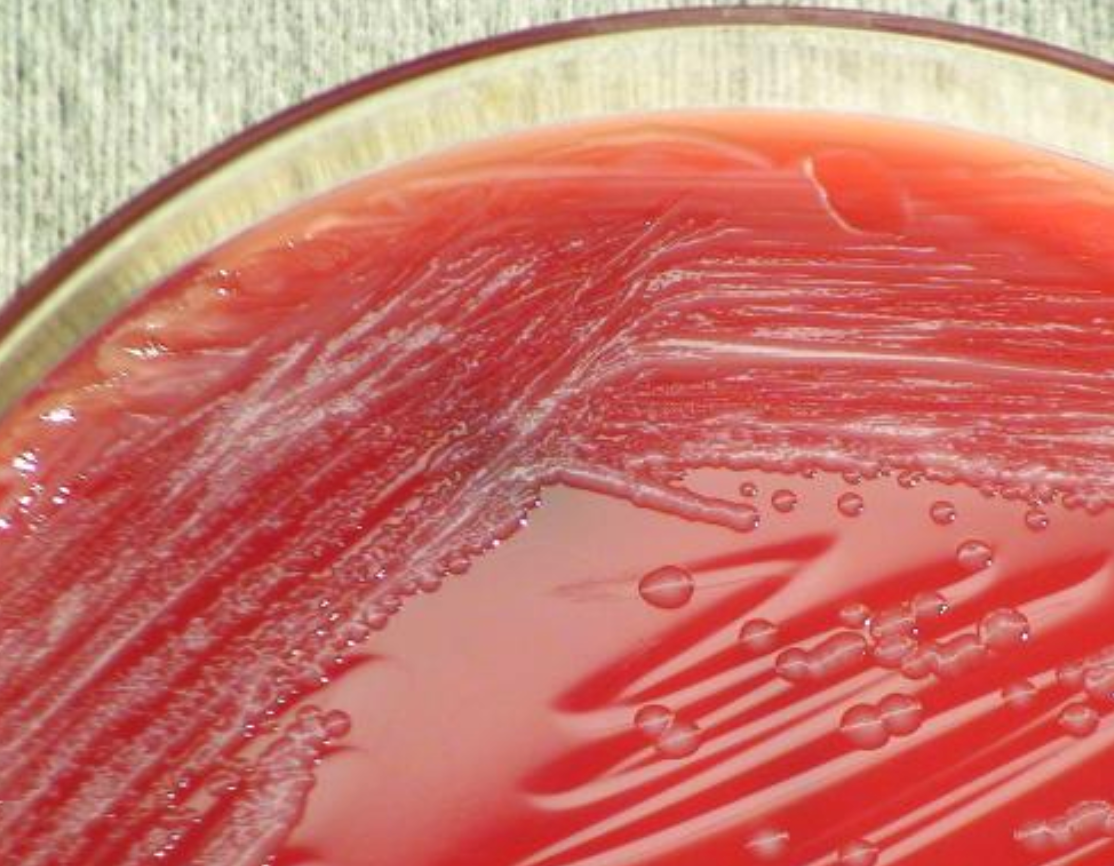

This photograph depicts the colonial morphology displayed by Gram-negative, Bordetella bronchiseptica bacteria.
Image credit: Pete Seidel/CDC
While most people associate Bordetella with whooping cough in humans, its lesser-known cousin, Bordetella bronchiseptica, quietly causes significant respiratory disease across species—from kennel cough in dogs to opportunistic infections in humans— making it a rare but potentially clinically relevant pathogen at the crossroads of veterinary and human medicine.1-3 Bordetella bronchiseptica can also be initially confused in its clinical presentation with Bordetella pertussis, the primary pathogen causing whooping cough.1,2 Given how rare B bronchiseptica is to isolate in humans and the unique treatment considerations, it is important for the clinician to review the risk factors, treatment, and preventative care of B bronchiseptica.1,2,4 This article aims to provide a summary of B bronchiseptica, how it differs from B pertussis, and review the literature for human cases of treatment of B bronchiseptica.
Bordetella bronchiseptica is a Gram-negative, motile coccobacillus that belongs to the same genus and family as B pertussis and B parapertussis, the causative organisms for whooping cough.1,2,5,6 Bordetella bronchiseptica is commonly found in the respiratory tract of mammals, mainly household dogs and cats, and is a known pathogen causing kennel cough.3,6 Pets, especially those vaccinated with the live vaccine, are considered the main vector for transmission to humans, though the organism can be transmitted through other humans and fomites.1,2,6 While subjected to sampling bias, since B bronchiseptica is rarely isolated in practice, much of the literature in humans has identified an immunocompromised state, such as HIV, cystic fibrosis, and transplant, as a risk factor for infection.1,2,6,7
Symptoms of infection with B bronchiseptica can have a wide presentation in humans, ranging from a dry hacking cough, dyspnea, fever, rhonchi, and pulmonary infiltrates.1,2 This clinical picture could be confused for more common infections in humans, such as community-acquired pneumonia (CAP) or whooping cough, both of which can potentially be treated with a macrolide such as azithromycin.5,8-10 However, since sputum cultures are not routinely obtained for CAP, especially non-severe CAP, it could be that the lack of isolation of B bronchiseptica is secondary to a lack of testing.10 Since B bronchiseptica was not reported in the CDC EPIC study of CAP etiology in the US, it is likely to be a rare cause of CAP in humans with most literature limited to case reports and series.4
In addition, while B pertussis is available on some molecular testing, such as expanded respiratory virus panels, B bronchiseptica is absent.5,11 If B. bronchiseptica were to be identified on bacterial cultures, samples may need to be sent to a reference laboratory for antimicrobial sensitivities. The Clinical & Laboratory Standards Institute (CLSI) provides breakpoint recommendations for antimicrobials against B bronchiseptica, but it is limited to veterinary breakpoint interpretations for antimicrobials which are largely not approved for human use.12 Since there are no existing guidelines for the treatment of B bronchiseptica in humans, clinicians may be tempted to empirically treat B bronchiseptica similarly to the related B pertussis, for which macrolides are first-line therapy.8,9 However, limited in vitro data suggest resistance to macrolides such as azithromycin.13,14 Veterinary guidance suggests first-line treatment of B. bronchiseptica with tetracyclines such as doxycycline.3 In addition to tetracyclines, fluoroquinolones also appear to have in vitro efficacy against B bronchiseptica.13,15
For evidence of clinical success in humans, the clinician is largely limited to case reports and case series for the empiric treatment of B bronchiseptica while waiting for sensitivities.1,15 Please refer to Table 1 for a brief review of the published literature in humans within the last decade. In some cases in Table 1, initial empiric treatment with macrolides was associated with clinical failure.5,16,22 In aggregate, the cases in Table 1 do seem to support the empiric use of tetracyclines or fluoroquinolones.5,7,16-26 Due to a lack of clinical success with azithromycin, this is likely an inadequate treatment option for B bronchiseptica, despite being the preferred treatment for B pertussis.

In addition to treatment considerations, it is helpful for the clinician to be able to provide risk mitigation strategies to prevent B bronchiseptica infection in patients at risk for development of significant disease. For example, immunocompromised patients with household pets should ensure the pet is seen by a veterinarian regularly and is up to date on their vaccinations. Since there is substantial variety in veterinary vaccines available, at risk patients should talk to their veterinarian about if the pet needs B bronchiseptica (aka kennel cough) vaccination, the type of vaccination (ex: live vs inactivated), the potential duration of pathogen transmission, and best practices to avoid zoonotic infection.6 Patients should also exercise caution around places with high transmission rates, such as pet daycare facilities and animal shelters. Surfaces that may be contaminated with B bronchiseptica should be cleaned with a household disinfectant.1,6 While animals can be vaccinated against B bronchiseptica, there is no commercially available human vaccine against this organism.1,6,27 Despite this, humans at risk for infection should be reviewed for general immunization recommendations. There is some hint in the literature that there is the potential for cross-protection from the pertussis vaccine.27
Albeit a rare infection, the chances of a patient being infected by B bronchiseptica are nonzero. With numerous challenges to the detection of B bronchiseptica as a causative pathogen for infection in humans, clinicians should take into consideration the patient’s immunocompromised status, social factors such as close contact with household pets, and immunization status against pertussis.1,2,6 Identification of the pathogen to the species level should be considered a priority step to avoid treatment with a potentially suboptimal antibiotic. Once B bronchiseptica is confirmed, then treatment with a tetracycline or fluoroquinolone is a reasonable empiric option based on the available literature.
References
-
Miguelena Chamorro B, De Luca K, Swaminathan G, Longet S, Mundt E, Paul S. Bordetella bronchiseptica and Bordetella pertussis: Similarities and Differences in Infection, Immuno-Modulation, and Vaccine Considerations. Clin Microbiol Rev. 2023;36(3):e0016422. doi:10.1128/cmr.00164-22
-
Woolfrey BF, Moody JA. Human infections associated with Bordetella bronchiseptica. Clin Microbiol Rev. 1991;4(3):243-255. doi:10.1128/CMR.4.3.243
-
Lappin MR, Blondeau J, Boothe D, et al. Antimicrobial Use Guidelines for Treatment of Respiratory Tract Disease in Dogs and Cats: Antimicrobial Guidelines Working Group of the International Society for Companion Animal Infectious Diseases. J Vet Intern Med. 2017;31(2):279-294. doi:10.1111/jvim.14627
-
Jain S, Self WH, Wunderink RG, et al. Community-Acquired Pneumonia Requiring Hospitalization among U.S. Adults. N Engl J Med. 2015;373(5):415-427. doi:10.1056/NEJMoa1500245
-
McNulty MC, Shibib DR, Steinbeck JL, et al. Misdiagnosis of Bordetella bronchiseptica Respiratory Infection as Bordetella pertussis by Multiplex Molecular Assay. Clin Infect Dis. 2018;67(12):1919-1921. doi:10.1093/cid/ciy469
-
Moore JE, Rendall JC, Millar BC. A doggy tale: Risk of zoonotic infection with Bordetella bronchiseptica for cystic fibrosis (CF) patients from live licensed bacterial veterinary vaccines for cats and dogs. J Clin Pharm Ther. 2022;47(2):139-145. doi:10.1111/jcpt.13492
-
Yacoub AT, Katayama M, Tran J, Zadikany R, Kandula M, Greene J. Bordetella bronchiseptica in the immunosuppressed population – a case series and review. Mediterr J Hematol Infect Dis. 2014;6(1):e2014031. doi:10.4084/MJHID.2014.031
-
Tiwari T, Murphy TV, Moran J; National Immunization Program, CDC. Recommended antimicrobial agents for the treatment and postexposure prophylaxis of pertussis: 2005 CDC Guidelines. MMWR Recomm Rep. 2005;54(RR-14):1-16.
-
Altunaiji S, Kukuruzovic R, Curtis N, Massie J. Antibiotics for whooping cough (pertussis). Cochrane Database Syst Rev. 2007;(3):CD004404. doi:10.1002/14651858.CD004404.pub3
-
Metlay JP, Waterer GW, Long AC, et al. Diagnosis and Treatment of Adults with Community-acquired Pneumonia. An Official Clinical Practice Guideline of the American Thoracic Society and Infectious Diseases Society of America. Am J Respir Crit Care Med. 2019;200(7):e45-e67. doi:10.1164/rccm.201908-1581ST
-
Mayo Clinic Laboratories. Test ID: RP Respiratory Panel, PCR, Nasopharyngeal. https://www.mayocliniclabs.com/test-catalog/overview/609409. Accessed September 4, 2025.
-
CLSI. Performance Standards for Antimicrobial Disk and Dilution Susceptibility Tests for Bacteria Isolated From Animals, 7th Edition. CLSI guideline VET01S. Clinical and Laboratory Standards Institute; 2024.
-
Kadlec K, Schwarz S. Antimicrobial Resistance in Bordetella bronchiseptica. Microbiol Spectr. 2018 Jul;6(4):10.1128/microbiolspec.arba-0024-2017. doi: 10.1128/microbiolspec.ARBA-0024-2017.
-
Dewan KK, Skarlupka AL, Rivera I, et al. Development of macrolide resistance in Bordetella bronchiseptica is associated with the loss of virulence. J Antimicrob Chemother. 2018 Oct 1;73(10):2797-2805. doi: 10.1093/jac/dky264. PMID: 30107601
-
PrĂĽller S, Rensch U, Meemken D, et al. Antimicrobial Susceptibility of Bordetella bronchiseptica Isolates from Swine and Companion Animals and Detection of Resistance Genes. PLoS One. 2015;10(8):e0135703. doi: 10.1371/journal.pone.0135703
-
Mohamed N, Juan MRS, Navarathna DH. Multifocal pneumonia caused by Bordetella bronchiseptica: Insights from a human case study. IDCases. 2024;37:e02030. doi:10.1016/j.idcr.2024.e02030
-
Tatem LL, Veale T, Richardson C, Luckhardt T. Canine acquired pneumonia caused by Bordetella bronchiseptica. IDCases. 2023;34:e01922. doi:10.1016/j.idcr.2023.e01922
-
Barcala Salido JM, Mora-Delgado J, Lojo-Cruz C. Bordetella bronchiseptica pneumonia in an immunocompetent pig farmer. IDCases. 2022;27:e01435. doi:10.1016/j.idcr.2022.e01435
-
Chan KH, Ajao SO, Farouji I, Slim J. A Case of Bordetella bronchiseptica Bacteremia in a Patient With Decompensated Liver Cirrhosis. Cureus. 2021;13(3):e13938. doi:10.7759/cureus.13938
-
Gujju VR, Akram B, Shibib DR, McGhee MA, Drevets DA. Bordetella bronchiseptica infections in patients with HIV/AIDS: A case report and review of the literature. Medicine (Baltimore). 2021;100(51):e28244. doi:10.1097/MD.0000000000028244
-
Woods P, Ordemann K, Stanecki C, Brown J, Uzodi A. Bordetella bronchiseptica Pneumonia in an Adolescent: Case Report and Review of the Pediatric Literature. Clin Pediatr (Phila). 2020;59(3):322-328. doi:10.1177/0009922819897355
-
Clements J, McGrath C, McAllister C. Bordetella bronchiseptica pneumonia: beware of the dog!. BMJ Case Rep. 2018;2018:bcr2018224588. doi:10.1136/bcr-2018-224588
-
Monti M, Diano D, Allegrini F, et al. Bordetella bronchiseptica pneumonia in a patient with lung cancer; a case report of a rare infection. BMC Infect Dis. 2017;17(1):644. doi:10.1186/s12879-017-2736-7
-
Rampelotto RF, Hörner A, Hörner C, Righi R, Hörner R. Pneumonia caused by Bordetella bronchiseptica in two HIV-positive patients. Sao Paulo Med J. 2016;134(3):268-272. doi:10.1590/1516-3180.2015.02492701
-
Ito Y, Uemura K. Successful treatment of Bordetella bronchiseptica pneumonia by minocycline in anti-neutrophil cytoplasmic antibodies-associated vasculitis patient. J Infect Chemother. 2016;22(12):808-810. doi:10.1016/j.jiac.2016.06.008
-
Matic NA, Bunce PE. Isolation of Bordetella bronchiseptica from blood and a pancreatic abscess. J Clin Microbiol. 2015;53(5):1778-1780. doi:10.1128/JCM.00175-15
-
Moore JE, Rendall JC, Millar BC. Does Bordetella pertussis vaccine offer any cross-protection against Bordetella bronchiseptica? Implications for pet owners with cystic fibrosis. J Clin Pharm Ther. 2021;46(5):1194-1198. doi:10.1111/jcpt.13350